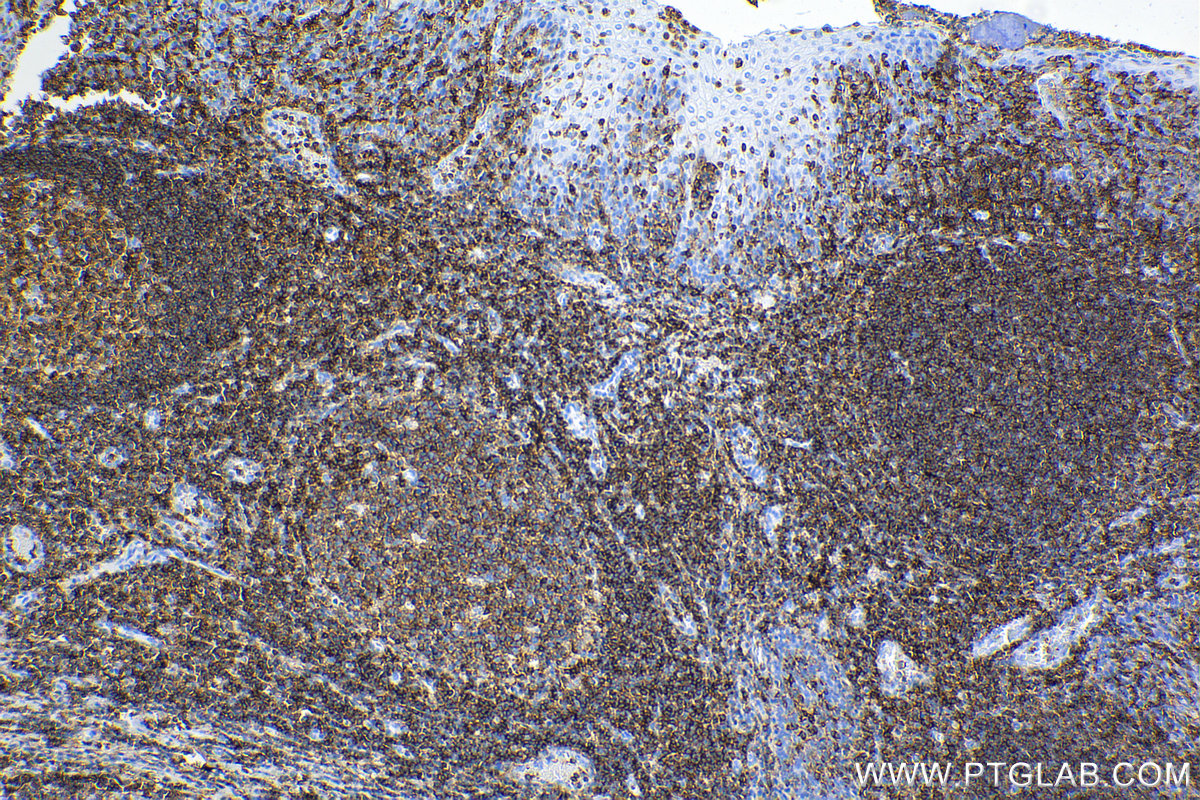
Immunohistochemical analysis of paraffin-embedded human tonsil tissue slide using <a class='green' href='/productredirect?CatalogNo=98117-1-RR' target='_blank'>98117-1-RR</a> (CD45 antibody) at dilution of 1:500 (under 10x lens). Heat mediated antigen retrieval with Tris-EDTA buffer (pH 9.0). This data was developed using the same antibody clone with 98117-1-PBS in a different storage buffer formulation. IHC staining of human tonsil using 98117-1-RR (same clone as 98117-1-PBS)

验证数据展示
产品信息
98117-1-PBS targets CD45 in IHC, IF/ICC, FC applications and shows reactivity with human samples.
| 经测试应用 | IHC, IF/ICC, FC Application Description |
| 经测试反应性 | human |
| 免疫原 |
CatNo: Eg2486 Product name: recombinant human CD45(220-577) protein Source: mammalian cells-derived, pHZ-KIsec-C-6*HIS Tag: C-6*HIS Sequence: 种属同源性预测 |
| 宿主/亚型 | Rabbit / IgG |
| 抗体类别 | Recombinant |
| 产品类型 | Antibody |
| 全称 | protein tyrosine phosphatase, receptor type, C |
| 别名 | EC:3.1.3.48, GP180, L CA, LCA, L-CA |
| 计算分子量 | 147 kDa |
| 基因名称 | CD45 |
| Gene ID (NCBI) | 5788 |
| ENSEMBL Gene ID | ENSG00000081237 |
| RRID | AB_3672264 |
| 偶联类型 | Unconjugated |
| 形式 | Liquid |
| 纯化方式 | Protein A purfication |
| UNIPROT ID | P08575 |
| 储存缓冲液 | PBS only, pH 7.3. |
| 储存条件 | Store at -80°C. The product is shipped with ice packs. Upon receipt, store it immediately at -80°C |
背景介绍
CD45, also known as protein tyrosine phosphatase, receptor type C, is a type I transmembrane protein expressed on the surface of all haematopoietic cells with the exception of erythrocytes and platelets (PMID: 3489673; 28615666). CD45 is a pan-haematopoietic cell marker and has been shown to be essential for T- and B-cell activation and signalling (PMID: 9429890; 16378097).